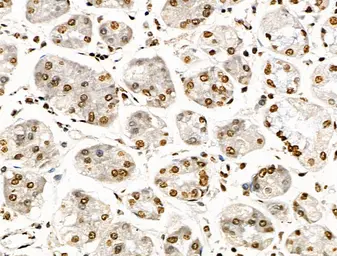

Histone H3K9K14K23K27ac (Acetyl Lys9/Lys14/Lys23/Lys27) antibody
Cat. No. GTX02535
Cat. No. GTX02535

GTX02535 WB Image
WB analysis of extracts from various samples using GTX02535 Histone H3K9K14K23K27ac (Acetyl Lys9/Lys14/Lys23/Lys27) antibody.
Lane 1 : Heat-shock treated EC304 cells, blocked with antigen-specific peptides
Lane 2 : Heat-shock treated EC304 cells
Lane 3 : UV treated A2780 cells
Lane 4 : UV treated RAW264.7 cells
6 / 24
-
HostRabbit
-
ClonalityPolyclonal
-
IsotypeIgG
-
ApplicationsWB ICC/IF IHC-P
-
ReactivityHuman, Mouse, Rat